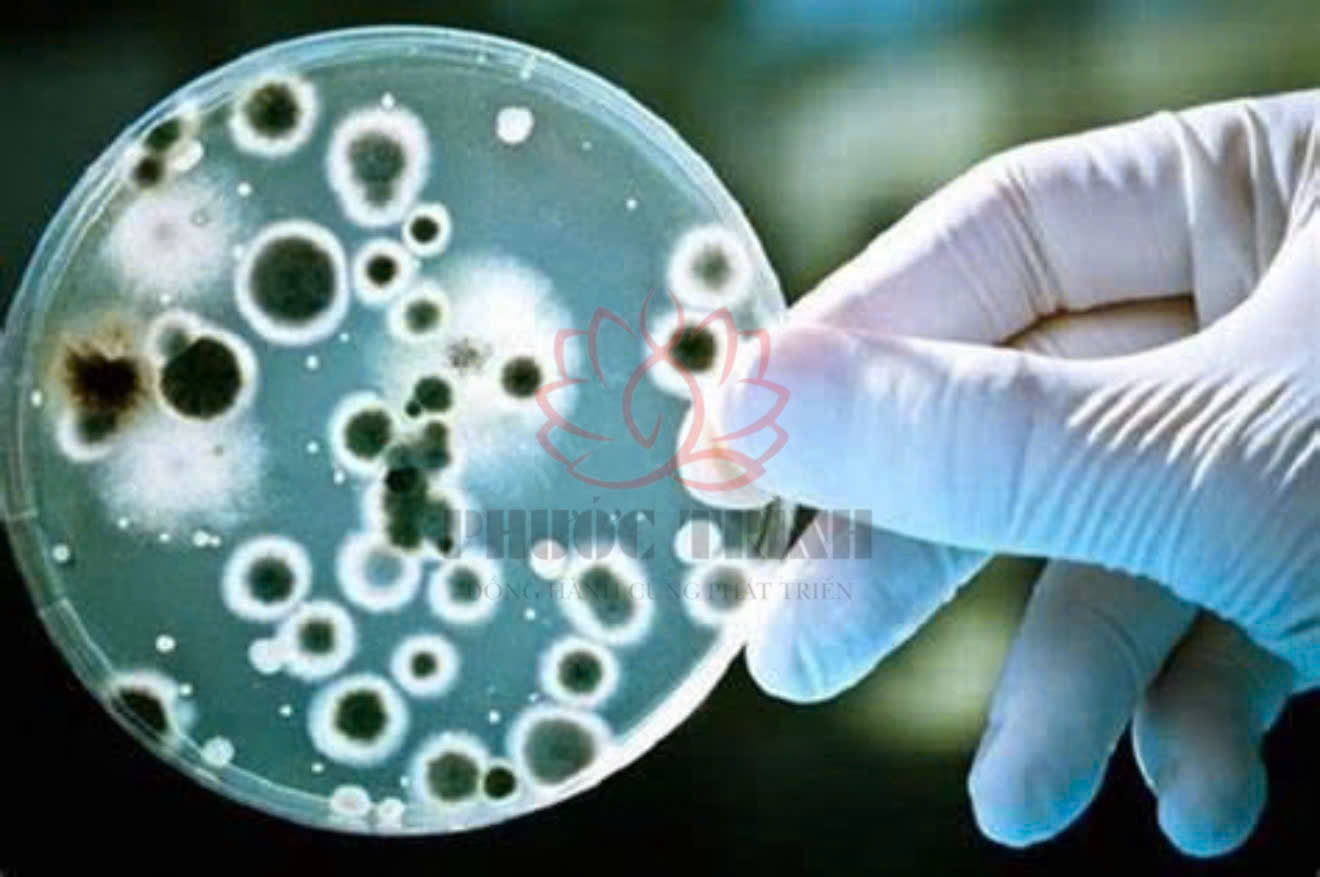

Thứ 6, 27/03/2026
Administrator
5
Bùn hoạt tính là một loại bùn sinh học được sinh ra trong quá trình xử lý nước thải bằng phương pháp sinh học. Bùn hoạt tính là một tập hợp các vi sinh vật tự nhiên, bao gồm vi khuẩn, protozoa và nấm, có khả năng phân hủy các chất hữu cơ trong nước thải.
Bùn có dạng hạt bông, kích thước từ 0,1 đến 1 mm. Các hạt bông bùn có khả năng kết dính với nhau, tạo thành các khối lớn hơn.

Quá trình bao gồm hai giai đoạn chính:

|
Yếu tố |
Ảnh hưởng |
|
Chất dinh dưỡng |
Chất dinh dưỡng cần thiết cho sự phát triển và sinh trưởng của vi sinh vật trong bùn hoạt tính. Các chất dinh dưỡng quan trọng nhất bao gồm: C, N, P, K. Sự thiếu hụt chất dinh dưỡng sẽ làm giảm hiệu quả xử lý nước thải. |
|
Thời gian lưu nước |
Thời gian lưu nước là khoảng thời gian nước thải lưu thông trong hệ thống xử lý bùn hoạt tính. Thời gian lưu nước phù hợp sẽ giúp vi sinh vật có đủ thời gian để phân hủy các chất hữu cơ trong nước thải. Thời gian lưu nước quá ngắn sẽ không đủ thời gian cho vi sinh vật phân hủy hết các chất hữu cơ, dẫn đến hiệu quả xử lý nước thải kém. |
|
Nhiệt độ |
Nhiệt độ ảnh hưởng đến tốc độ sinh trưởng và phát triển của vi sinh vật. Nhiệt độ tối ưu cho sự phát triển của vi sinh vật là 25-35 độ C. Nhiệt độ quá cao hoặc quá thấp sẽ làm giảm hiệu quả xử lý nước thải. |
|
pH |
pH là độ axit hoặc bazơ của môi trường. pH phù hợp cho sự phát triển của vi sinh vật trong bùn là 6,5-8,5. pH quá cao hoặc quá thấp sẽ làm giảm hiệu quả xử lý nước thải. |
|
Độc tố |
Một số chất độc có trong nước thải có thể gây hại cho vi sinh vật trong bùn hoạt tính, làm giảm hiệu quả xử lý nước thải. Các chất độc thường gặp bao gồm: kim loại nặng, hóa chất, thuốc trừ sâu,... |
|
Vi sinh vật |
Sự đa dạng và cân bằng của quần thể vi sinh vật trong bùn hoạt tính là rất quan trọng cho hiệu quả xử lý nước thải. Sự thay đổi về thành phần vi sinh vật có thể làm giảm hiệu quả xử lý nước thải. |
Ngoài các yếu tố trên, một số yếu tố khác cũng có thể ảnh hưởng bao gồm:
Việc kiểm soát các yếu tố ảnh hưởng đến bùn hoạt tính là rất quan trọng để đảm bảo hiệu quả xử lý nước thải.
Màu sắc của bùn có thể biến đổi từ nâu đỏ đến đen, xám, xanh lá cây,...
|
Màu sắc |
Nguyên nhân |
Hiện tượng |
Kết quả |
|
Nâu đỏ |
Hệ vi sinh đạt trạng thái cân bằng |
Hiệu quả xử lý nước thải tốt |
Không ảnh hưởng |
|
Đen |
Vi sinh vật kỵ khí phát triển |
Tạo ra sản phẩm phụ có mùi hôi và màu đen |
Giảm hiệu quả xử lý nước thải, gây mùi hôi |
|
Xám |
Vi sinh vật hiếu khí chết đi |
Giảm hiệu quả xử lý nước thải |
Tăng khả năng tạo ra sản phẩm phụ có mùi hôi |
|
Xanh lá cây |
Tảo phát triển |
Tạo ra oxy, nhưng cũng có thể sản sinh ra chất độc hại |
Giảm hiệu quả xử lý nước thải, gây mùi hôi |

Ngoài ra, màu sắc có thể bị ảnh hưởng bởi các chất hữu cơ có trong nước thải. Ví dụ, nếu nước thải có chứa nhiều chất hữu cơ có màu sắc, chẳng hạn như dầu mỡ, thì bể bùn hoạt tính cũng sẽ có màu sắc tương tự.
Để xác định chính xác nguyên nhân đổi màu, cần tiến hành kiểm tra chất lượng bùn hoạt tính. Các chỉ tiêu cần kiểm tra bao gồm:
Hiện tượng bùn hoạt tính đổi màu có thể dẫn đến các kết quả sau:


Có nhiều công nghệ xử lý nước thải bằng bùn hoạt tính khác nhau, tùy thuộc vào loại nước thải, thành phần của nước thải và yêu cầu về chất lượng nước thải đầu ra.
.jpg)
.jpg)
Các loại vi khuẩn chính trong bùn hoạt tính bao gồm:
|
Loại Vi Khuẩn |
Yêu Cầu Oxy |
Môi Trường Sinh Trưởng |
Nhiệm Vụ Chính |
|
Vi khuẩn hiếu khí |
Cần Oxy |
Môi trường có oxy |
Phân hủy chất hữu cơ, bao gồm protein, chất béo, và carbohydrate |
|
Vi khuẩn kỵ khí |
Không cần Oxy |
Môi trường thiếu oxy |
Phân hủy chất hữu cơ trong điều kiện thiếu oxy |
|
Vi khuẩn yếm khí |
Có thể sinh trưởng trong môi trường có oxy hoặc không có oxy |
Môi trường có oxy thấp |
Phân hủy chất hữu cơ trong điều kiện có oxy thấp |
Một số vi khuẩn cụ thể thường được tìm thấy trong bùn hoạt tính bao gồm:
|
Vi khuẩn |
Chức năng |
|
Nitrosomonas |
Oxy hóa amoniac thành nitrit |
|
Nitrobacter |
Oxy hóa nitrit thành nitrat |
|
Pseudomonas |
Phân hủy chất hữu cơ, bao gồm cả khó phân hủy |
|
Bacillus |
Phân hủy chất hữu cơ, bao gồm cả khó phân hủy |
|
Flavobacterium |
Phân hủy chất hữu cơ, bao gồm cả khó phân hủy |
Sự cân bằng của các nhóm vi khuẩn trong bùn hoạt tính là rất quan trọng để đảm bảo hiệu quả xử lý nước thải. Nếu tỷ lệ vi khuẩn yếm khí quá cao, có thể làm giảm hiệu quả của quá trình oxy hóa amoniac và nitrat.
Xử lý nước thải bằng bùn hoạt tính có nhiều lợi ích, bao gồm:
Tuy nhiên, xử lý nước thải bằng bùn hoạt tính cũng có một số hạn chế, bao gồm:
Nếu bạn quan tâm đến hệ thông xử lý nước thải, hãy liên hệ với Môi trường Phước Trình để được tư vấn miễn phí và hỗ trợ kĩ thuật.
.jpg)